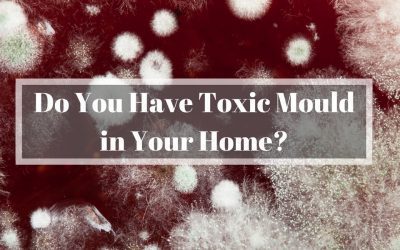
Toxic Mould – How Safe Is Your Home?

LeakDtech Growth Hub
Self-Help Videos
Blogs
Resources
Newsletter
Featured Episode
Residential High Bills
Make sure you take a look at the main tank and all your taps in case there is a leak in the garden, or alternatively make sure none of your toilets or shatafs are running.
Season 2, Episode 4 | 38min
Read Our Blogs
Interstitial Condensation – Why Should We Worry?
Humidity within some hot climates can cause secondary damp, mould and interstitial condensation if buildings are not sealed correctly, LeakDtech Dubai can help solve all these problems
Malls, Schools & Hotels – Is Your Atrium Leaking?
LeakDtech’s leak detection experts can scan atrium in Malls, Schools and pinpoint leaks, utilising new innovative technology that uses either smoke, ultrasonics or smoke from the ground for the leak detection. Is your atrium leaking? Learn more about atrium leakages in our blog.
Asbestos Plus Water – A Lethal Duo
It is a common fact that asbestos is poisonous & harmful to people, with the inhalation of fibres causing serious illness. Schools, in particular, older schools, are more likely to have asbestos fibres in the building foundations, mostly in the roofs, ceilings & walls where asbestos lagging may have been utilised.
Health Issues For School Children Following School Flooding
Installing a leak detection system which uses modern technology to prevent school flooding can create a safer learning environment for children…
Toxic Mould – How Safe Is Your Home?
Water leaks cause damp walls or even wet walls that can lead to growth of toxic mould with the right conditions. With toxic mould how safe is your home?
Managing Leaks In A Commercial Pool
Commercial pool leak detection specialists of LeakDtech Dubai can quickly locate leaks in commercial pools, so they can remain open for business
Additional Resources
Read the LeakDtech Brochure
Read the Latest Global Climate & Environmental News
BBC • The Guardian • NASA Climate • Mongabay
- US is ‘using Mexico as a garbage sink’ leading to ‘toxic crisis’, UN expert saysby Verónica García de León and Erin McCormick on April 7, 2026 at 10:00 am
Marcos Orellana, a special rapporteur, found lax environmental standards and lack of oversight allowed pollution to accumulateMexico is facing a “toxic crisis” and has become a “garbage sink” for the US, exposing Mexican communities to dangerous pollution, a UN expert has warned.In an interview with the Guardian and Quinto Elemento Lab, an investigative outlet, Marcos Orellana, an environmental specialist, said pollutants ranging from imported waste to dangerous pesticides are affecting people’s right to live healthy lives. Continue reading...
- A new economic superpower could spark a global retreat from fossil fuels | Mark Hertsgaard and Kyle Popeby Mark Hertsgaard and Kyle Pope on April 7, 2026 at 10:00 am
Eighty-five countries have sought a roadmap to phasing out fossil fuels. A conference this month offers hope they could uniteThis article is published as part of the global journalism collaboration Covering Climate NowThe Iran war is also a climate war. Beyond its terrible human costs, the war’s disruptions of oil, gas, fertilizer and other shipments is another reminder of the risks inherent in basing the world economy on fossil fuels. The war’s jets, missiles and aircraft carriers, and the tankers, refineries and buildings they blow up, represent millions of tons of greenhouse gas emissions that further imperil a climate system that is already “very close” to a point of no return, scientists say, after which runaway global warming could not be stopped. Nevertheless, petrostate leaders around the world continue doing their utmost to stave off a desperately needed course correction.Now, a little noticed ray of hope may be peeking over the horizon.Mark Hertsgaard and Kyle Pope are co-founders of the global journalism collaboration Covering Climate Now Continue reading...
- Indigenous governance key to protecting Amazon Basin connectivity, experts sayby Alexandrapopescu on April 7, 2026 at 9:36 am
In the southern tip of Colombia’s Cauca department, known as the “boot” for its shoe-like shape, volunteer members of an Indigenous guard patrol their territories in the Andean foothills to protect them from invasion and deforestation. The municipality of Piamonte, which covers most of the boot, suffered the highest loss of forest cover in Cauca
- Wildlife concerns remain after Kenya court ruling over luxury safari campby Elodietoto on April 7, 2026 at 9:13 am
This is the end of a saga that has stirred nature and tourism enthusiasts in Kenya for the past six months. The Environment and Land Court at Narok dismissed a petition filed in August 2025 by Meitamei Olol Dapash, director of the Institute for Maasai Education, Research and Conservation. The environmentalist had opposed the opening
- What are UV levels and how can you protect yourself?on April 7, 2026 at 8:49 am
How dangerous is UV radiation and how can you protect yourself when levels are high?
- Artemis II crew head for home after travelling further from Earth than anyone beforeon April 7, 2026 at 6:33 am
The Artemis II crew go further than any humans before in Nasa's first crewed mission to the Moon in over 50 years.
- Artemis II crew head for home after travelling further from Earth than anyone beforeon April 7, 2026 at 6:33 am
The Artemis II crew go further than any humans before in Nasa's first crewed mission to the Moon in over 50 years.
- 'World first' gene project helping rare monkeyson April 7, 2026 at 5:32 am
Mapping the DNA of Crinkle, a Barbary macaque at Trentham Monkey Forest, will fight wildlife crime.
- Beavers return to county for first time in 400 yearson April 7, 2026 at 4:21 am
The "ecosystem engineers" are released on the Southill Estate after two years of careful planning.
- A human rights center opens a path to justice for Indigenous Peoples in the Central African Republicby Christophe Assogba on April 7, 2026 at 4:12 am
BAYANGA, Central African Republic — Across the Congo Basin, conservation has long been fraught with a difficult contradiction. Protected areas, meant to preserve wildlife, have at times also been the scene of allegations of human rights violations against Indigenous peoples. Over the past decade, Mongabay has documented allegations of beatings, intimidation and other abuses linked
- Drought Parches Floridaby Lauren Dauphin on April 7, 2026 at 4:01 am
The state was unusually dry for much of 2025, but the intensity of the drought has ratcheted up since January 2026. The post Drought Parches Florida appeared first on NASA Science.
- Artemis II Flight Day 6: Crew Wraps Historic Lunar Flybyon April 7, 2026 at 3:46 am
The Artemis II mission wrapped up a historic seven-hour lunar flyby, marking humanity’s first return to the Moon since Apollo 17 in 1972 and capturing images of the lunar far side. After the lunar observation period concluded, the Artemis II crew was congratulated by President Donald J. Trump, in a live conversation that aired as The post Artemis II Flight Day 6: Crew Wraps Historic Lunar Flyby appeared first on NASA Science.
- Is the Galápagos damselfish extinct?by Rhett Butler on April 7, 2026 at 1:06 am
A small, blue-gray fish that once gathered in loose schools along the rocky shores of the Galápagos Islands has become the subject of a more precise question: whether it is already gone. The Galápagos damselfish (Azurina eupalama) has not been recorded since 1983. Before that, it was regularly encountered. Specimens were collected by nearly
- Watch: Artemis II mission loses contact with Earth for 40 minuteson April 7, 2026 at 1:03 am
Once contact was regained, astronaut Christina Koch said: "It is so great to hear from Earth again."
- Crew Kicks Off Week Prepping for Cygnus Cargo Missionon April 6, 2026 at 10:49 pm
The Expedition 74 crew continues preparing for the next U.S. cargo mission due to visit the International Space Station. The orbital residents also serviced spacesuits, configured scientific hardware, and studied how microgravity affects blood pressure at the beginning of the week. The post Crew Kicks Off Week Prepping for Cygnus Cargo Mission appeared first on NASA Science.
- Camera traps take first photos of rare island antelope on Zanzibar by Bobbybascomb on April 6, 2026 at 9:53 pm
Conservationists have captured the first camera trap images of the highly elusive Pemba blue duiker, a tiny antelope that lives in a remnant of native forest in the north of Zanzibar’s Pemba Island. Standing just 30 centimeters (12 inches) high at the shoulder, the Pemba blue duiker is possibly a subspecies of the blue duiker
READ OUR NEWSLETTER
Coming soon!
Stay Connected with LeakDtech
Schedule an immediate quotation now